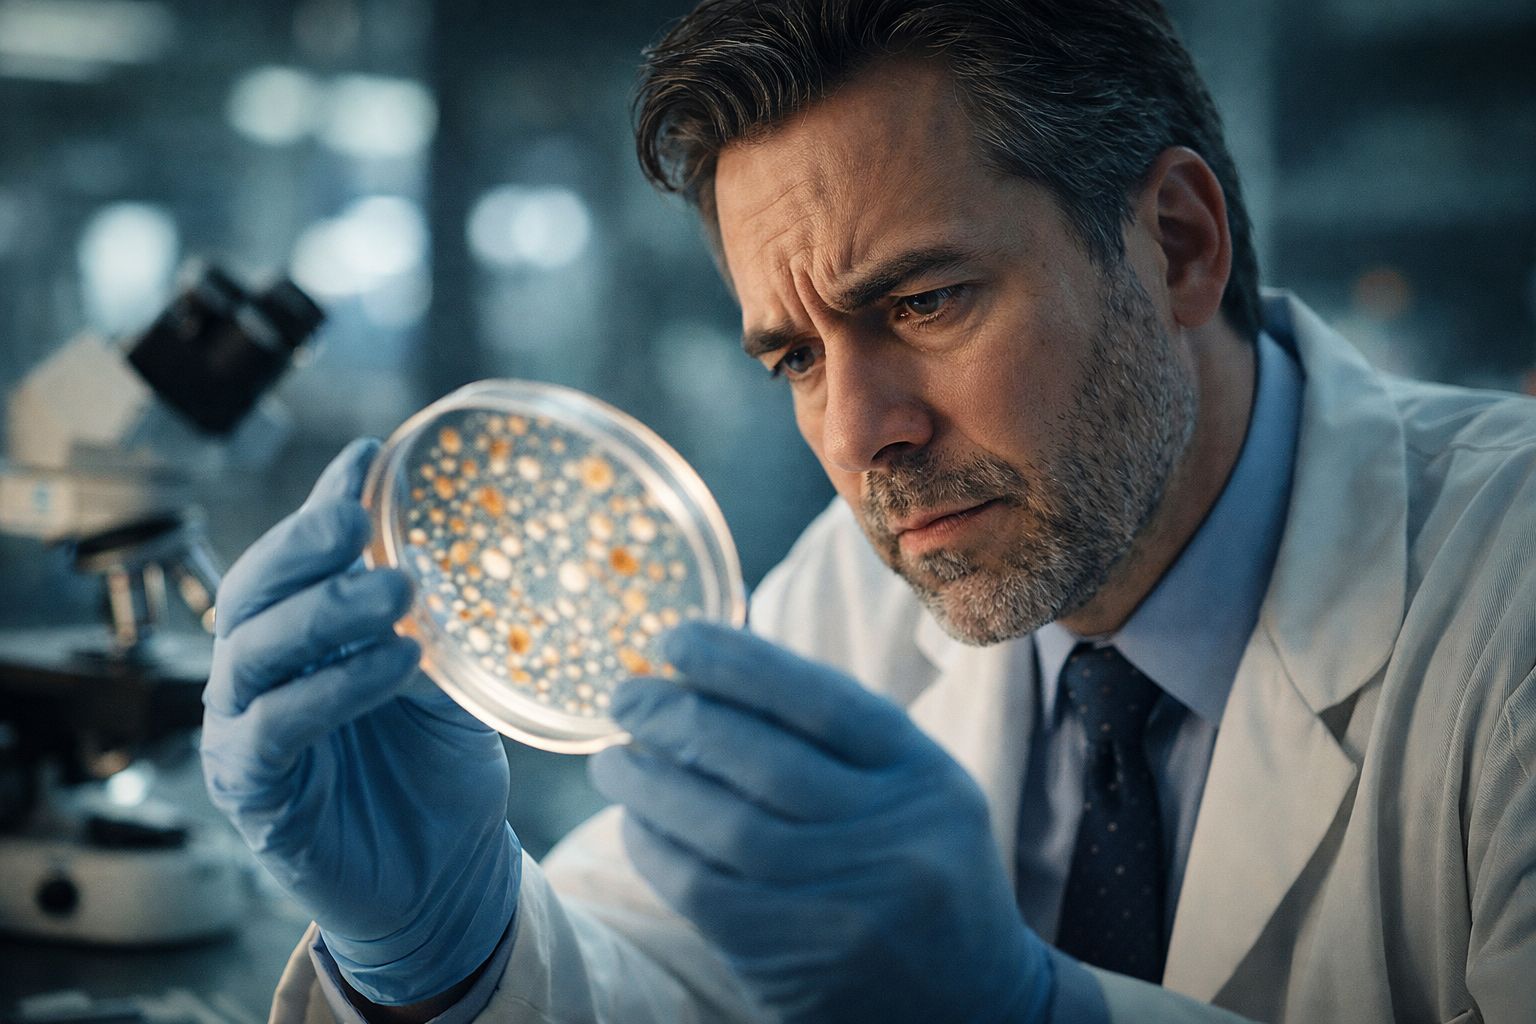

Vos Tupperware au lave-vaisselle : ce cocktail toxique invisible qui s’invite à table
Auteur: Adam David
Une habitude quotidienne… peut-être pas si anodine

On le fait tous, non ? Après le dîner, on balance machinalement nos boîtes en plastique, les fameux restes du midi, directement dans le lave-vaisselle. C’est pratique, c’est léger, ça ne casse pas. On ne se pose même pas la question. Pourtant, ce geste, qui nous semble si banal, est peut-être en train de nous empoisonner à petit feu. C’est du moins ce que suggère une nouvelle vague de recherches assez alarmantes sur la diffusion massive de micro et nanoplastiques. C’est une pollution silencieuse, invisible à l’œil nu, mais dont les conséquences commencent à peine à être comprises.
Il faut dire que les microplastiques, on ne peut plus vraiment les ignorer aujourd’hui. On sait déjà qu’on en respire, qu’on en boit, et qu’on en avale sans même s’en rendre compte. Je me souviens avoir lu des travaux de 2021 montrant que nous inhalerions chaque jour entre 2 000 et 7 000 microplastiques. C’est vertigineux quand on y pense. Ces particules, qui font moins de 5 millimètres, viennent de partout : nos emballages, les bouteilles de soda, les sachets de thé… et même nos chewing-gums ! Tout au long de sa vie, et même quand on croit bien faire en le recyclant, le plastique relâche ses fragments.
Et ça va plus loin. En juin 2025, une étude publiée dans la revue Human Reproduction a vraiment enfoncé le clou. Des chercheurs espagnols ont carrément retrouvé des microplastiques dans le liquide folliculaire et le liquide séminal. Ça fait froid dans le dos, honnêtement. Ça prouve que l’exposition est chronique, généralisée, intime même. Alors, imaginer qu’on en retrouve dans les eaux usées en sortie de nos machines à laver, ce n’est finalement, hélas, plus une surprise pour personne.
Chaleur et détergents : la machine infernale ?

Mais revenons à notre cuisine. C’est une étude récente, parue dans la très sérieuse revue American Chemical Society ES&T Water, qui pointe spécifiquement le lave-vaisselle du doigt. Pourquoi ? Eh bien, réfléchissez à ce qui se passe une fois la porte fermée. C’est un environnement hostile là-dedans : vos boîtes sont soumises à des températures qui peuvent grimper jusqu’à 70 °C, bombardées par des jets d’eau puissants et attaquées par des détergents abrasifs.
Le résultat de ce traitement de choc est sans appel. D’après les chercheurs, un seul et unique cycle de lavage contenant seulement des articles en plastique pourrait libérer environ 920 000 micro et nanoparticules dans les eaux usées. Presque un million en une seule fois ! Si on ramène ça à l’échelle d’un foyer normal, comme le vôtre ou le mien, cela représenterait jusqu’à 33 millions de particules par an.
Alors, je vous vois venir : « C’est grave docteur ? » En termes de masse pure, ce n’est pas énorme. Cela équivaut à environ 6 milligrammes de plastique par personne et par an. Pour vous donner une image, c’est à peu près le quart du poids d’un grain de riz. Une quantité qui semble infime, ridicule même, mais le problème, c’est l’accumulation. Jour après jour, lavage après lavage, ça s’empile dans l’environnement.
Les risques pour la santé : faut-il s’inquiéter ?
C’est là que le Dr Elvis Okoffo intervient. Il travaille pour l’Alliance du Queensland pour les sciences de la santé environnementale et il a publié un communiqué assez éclairant sur le site de l’université australienne. Il explique clairement : « Nous avons démontré que les contenants et les ustensiles en plastique lavés au lave-vaisselle libèrent des particules de plastique ». Ce qui est fou, c’est qu’avant ça, on ne considérait même pas nos lave-vaisselles comme une source de pollution plastique.
Le Dr Okoffo souligne que même nos actions quotidiennes, celles qui paraissent inoffensives, ont des effets cumulatifs. Il reste toutefois mesuré, nuançant que « malgré le nombre élevé de particules libérées, la masse totale libérée par les contenants en plastique est faible et mineure par rapport aux autres sources connues ». Mais le risque potentiel pour la santé humaine est bien là. Au-delà de l’écologie, on parle ici de notre corps. Une exposition prolongée est suspectée de favoriser tout un tas de problèmes peu réjouissants : réactions inflammatoires, troubles pulmonaires, maladies auto-immunes… on parle même de certains cancers, notamment celui de la vessie.
Et ce n’est pas tout. Une autre étude, parue dans Applied and Environmental Microbiology, a montré que ces fameux microplastiques pourraient même contribuer au phénomène d’antibiorésistance. C’est un cercle vicieux.
Conclusion : vers de nouvelles habitudes ?

Alors, on fait quoi ? On jette tout et on revient à l’âge de pierre ? Pas forcément. Face à ces constats un peu plombants, les chercheurs évoquent des pistes concrètes. On parle par exemple d’intégrer des filtres directement dans les lave-vaisselles pour piéger ces particules avant qu’elles ne partent dans les égouts. Ou alors, c’est à l’industrie de développer des plastiques beaucoup plus résistants à l’abrasion et à la chaleur.
Comme le conclut le Dr Okoffo avec une note d’espoir : « De petits changements, lorsqu’ils sont appliqués à des millions de foyers, peuvent contribuer à réduire le fardeau mondial de la pollution plastique ». En attendant ces innovations, peut-être que laver nos vieilles boîtes à la main, ou passer progressivement au verre, n’est pas une si mauvaise idée. C’est un petit effort, je suppose, mais si ça peut éviter d’assaisonner nos repas au plastique…
Selon la source : aufeminin.com
Ce contenu a été créé avec l’aide de l’IA.